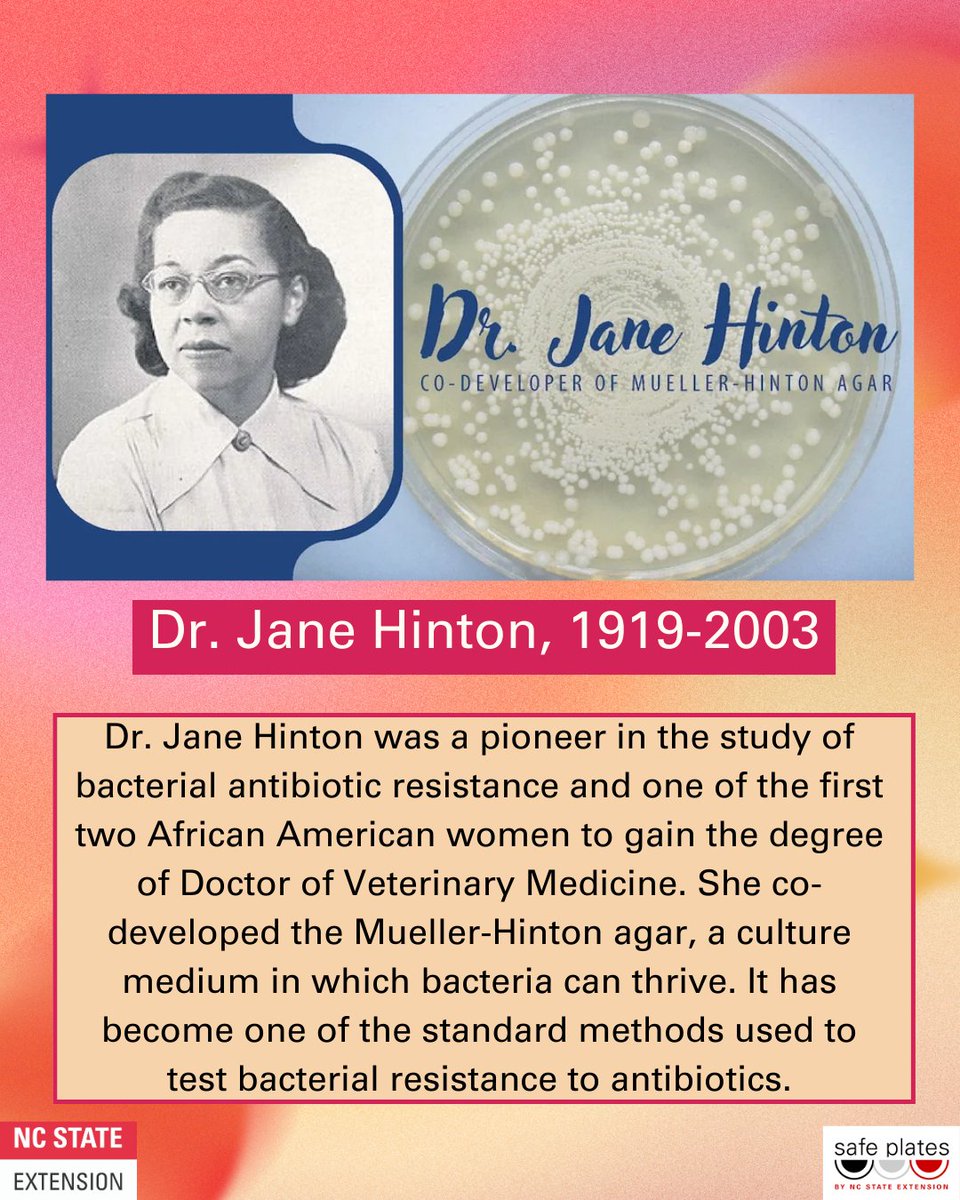
Safe Plates Food Safety Information Center tweet media

Happy National Wine and Cheese Day! 🍷🧀 Here's Our Food Safety Guide to Serving Charcuterie Boards!
#wineandcheeseday #charcuterie #cheeseboard #winelovers #grazeboard #food #foodsafety




English
Safe Plates Food Safety Information Center
3.3K posts

@SafePlatesFSIC
A practical approach to sharing science-based food safety information to anyone that eats. Developed and run by NC State Extension. 🐺#FoodSafety